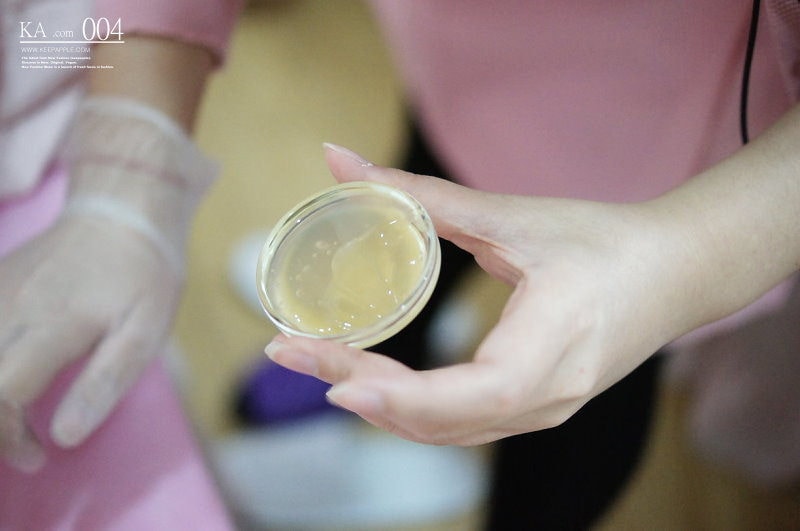
DSC02534

夏天快到了,總覺得還是去雷射最一勞永逸
第一次做雷射除毛好像是去年十月還是十一月吧
確切的時間有點忘記了,但的確離現在已經有點久
之前我也陸陸續續使用過很多除毛用品
但還是覺得不能根治挺麻煩的,一直想要去除毛
尤其是小黑頭,跟粉刺一樣都是拔了會繼續生長XD
終於找到時間就趕快去預約諮詢了
只能說雷射除毛是一個需要時間去做的事情
因為到現在為止我也才除了三次
大部分的人的都是要除六次才除乾淨
不過因為我做到現在效果已經很好了
再生長出來的毛髮也很少,所以就選擇先來跟你們分享囉
不然這篇可能要明年才能發了~阿哈哈


回顧一下
這是去年十月瘦瘦的腿
接近半年胖好多….=_=
我這半年也吃太好吧
把自己養得跟豬一樣orz
好啦我最近找回羞恥心了
希望六月前可以瘦身成功
我也不要太激烈的減肥方式
這樣很容易復胖,還是漸進式就好

先來跟大家說說雷射除毛的原理
毛囊的生長週期分為『生長期、過渡期、休止期』3期
雷射除毛主要是針對『生長期』的毛髮進行破壞
因為當毛髮處於成長階段時,毛囊的黑色素含量最高
雷射除毛的作用最好~所以需要分段式進行
每個人會因為毛量多寡進行不同次數的療程
平均需要4~8次的治療(每次間隔6~8週),可以達到最佳的除毛效果
然後護士會貼心的告訴你雷射除毛的方式與術後照顧,不用擔心太多啦!!

除毛前幾天必須先把毛刮乾淨
這樣才能來診所讓人除喔!!
我其實比起腋毛更在意腿毛
因為私底下我不常穿無袖的衣服
所以綺夢(?)跑出來SAY HELLO的次數不多
但是我很喜歡穿短裙和短褲因為怕熱
無限生長的腿毛(?)對我來說比較困擾是真的!!
夏天常常必須一兩天就要用美體刀除毛一次
BUT~這次我沒有除手毛,所以等之後真的有機會
搞不好我也會想把他除一除~~哈哈


這天到診所就開始療程了
首先就是先清潔
清潔之後上麻藥

麻藥通常會厚敷
停留30分鐘以上比較有效果

想要起來行動的孩子
美容師也會幫你用保鮮膜包起來

然後就可以放鬆地度過敷麻藥時間~
基本上要移動或是玩手機也是沒問題的

時間到了就是卸麻藥囉!


我這次是除小腿和腋毛
所以都是先從腋毛開始除起
因為雷射的光會傷害到眼睛
要先做好保護眼睛的措施
就是戴上鹹蛋超人眼罩

除完的地方都會紅紅的
很正常,過一陣子就會退


接著是除腿毛
還記得我第一次除最痛
可能是因為毛囊比較大(?)跟毛比較多的關係
不過後來看了大家的經驗分享
除毛都是第一次最痛,再來就還好
我也是這麼覺得,到第三次就覺得挺輕鬆的XD



通常是正面、反面除
醫生會看你那些地方還需要再加強
如果你腳趾頭有需要除
也可以先跟護士說麻藥也要敷到腳趾頭囉!!
(不過我是沒有拉~)

第一次效果就很好了
隔一個月腿毛才長出這些


再來是第二次
其實流程跟第一次差不多
我就不贅述了
總之第二次不痛很多
總結就是忍過第一次就好~~哈哈XD

這次來我還邊敷麻藥邊打美白針

….一整個非常不浪費時間

對了,如果是要做除毛的話
建議大家為了方便就穿小可愛或是背心來
這樣就不用特地換美容衣
因為這天我是穿洋裝來
就必須全部換掉~換上美容衣才比較方便流程



第二次打的時候
就覺得真的比第一次打的時候還要不痛
雖然我第一次跟第二次間隔有點久
記得有兩個月以上
不過那時候腋毛生長速度就變很慢了


整體來說,雷射除毛操作流程就是
1.治療部位清潔
2.上表面麻藥(30分鐘後)
3.卸麻藥
4.開始雷射除毛治療
5.冰敷

剛打完真的都還滿恐怖的
自己看到腿都會嚇一跳
很像長什麼紅斑~
不過冰敷之後就會退了
美容師也會幫你擦上舒緩的凝膠這樣

謎之音:
這姿勢擺久了…真的是會有點害羞==

接著
來分享一下我半年來三次除毛的成果吧!
術後保養的部分就是記得暫時不要碰三溫暖或溫泉
當然保濕工作也要記得做好囉
我是洗完澡一定會擦乳液的那種!
不要擦有美白成分,擦純粹保濕的乳液就好

效果最好的應該是綺夢(喂)
因為現在腋毛已經幾乎都沒有再生長了說
我已經很久很~~久沒除腋毛了
連家裡的除毛刀都不知道跑哪去~XD

再來是小腿的部分
我覺得比起之前的毛髮真的是少很多
因為我之前小腿毛是又粗又硬的那種
摸起來很像會扎人XD


雖然還是有一些些需要再補強
應該會再去作第四次的除毛
不過整體來說效果我已經很滿意了說
不細看完全不會注意到有腿毛這樣


肌膚近拍
感覺除毛以後真的會有視覺上變白的效果
因為整體來說變乾淨了吧

比起來
完全沒有除毛的手毛就很茂密XDD
不過還好我手毛算是細的啦
就沒有那麼CARE

夏天到了
我覺得果真的很想要一勞永逸的孩子
真的不妨考慮去雷射除毛一下
以後會輕鬆很多哩!!

分享一下我除毛的診所
其實我分別去了星采和星和
星和診所台北店: (02) 2388-7778
地址:台北市館前路2號6樓之一
星采診所古亭店: (02)-23671789
地址:116北市羅斯福路2段116號
星和部落格: http://starclinic100.pixnet.net/blog
星和粉絲團: http://www.facebook.com/starclinic.tw
那今天就分享到這邊拉
就以上♥♥♥
。AFTER TALK。
我覺得最近減肥遇到瓶頸了
一開始還覺得自己瘦得滿快的
但最近好像又太不忌口了
之後還要出去玩又會忍不住吃美食
一直在想瘦身又想要吃美食的念頭裡徘徊
人生就是這麼的矛盾阿~~(遠目)
最近重新開了一個二手拍社團
有興趣的孩子可以加入啦!!
這篇一樣有推+讚+留言獎
記得都要留言完整才可以參加抽獎
我會找時間會在粉絲團裡開獎^Q^
延伸閱讀時間
【醫美】完全不需要恢復期卻可以達到最深層效果。Ulthera極線音波拉皮❤
【醫美】一個月內可以看到的顯著變化。Ulthera極線音波拉皮的拉提效果

我的FB,可以來這邊找我玩耍喔↓↓↓↓↓↓↓↓
ヾ(コ´∀`)(ン´∀`)(ニ´∀`)(チ´∀`)(ヮ´∀`)ノ
聯絡EMAIL [email protected]
蘋果部落格 www.keepapple.com
蘋果粉絲團 http://www.facebook.com/cuterosalind
蘋果二手拍拍社團 http://ppt.cc/x8TL
打完收工
蘋果二手拍拍社團


